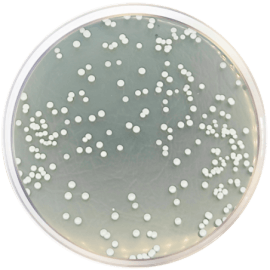
main product photo

Close
STANDARD METHODS AGAR WITH POWDERED MILK (ISO 4833) 500 grams/bottle
SKU
CDL/1033
Brand
CONDALAB
Pre-order (Deliver in 8 to 12 weeks)
Standard Methods agar with Powdered Milk is recommended by APHA and ISO 4833 for enumerating microorganisms in dairy products. It is used with the same techniques as the Standard Methods Agar.
Enzymatic digest of casein is a source of nitrogen, vitamins and minerals. Yeast extract provides vitamins especially the B-group. Glucose is a source of carbohydrate as energy source. Skimmed milk is a source of lactose and casein. Bacteriological agar is the solidifying agent.
Standard Methods agar with Powdered Milk is recommended by APHA and ISO 4833 for enumerating microorganisms in dairy products. It is used with the same techniques as the Standard Methods Agar.
Enzymatic digest of casein is a source of nitrogen, vitamins and minerals. Yeast extract provides vitamins especially the B-group. Glucose is a source of carbohydrate as energy source. Skimmed milk is a source of lactose and casein. Bacteriological agar is the solidifying agent.
| Brand | CONDALAB |
|---|
Write Your Own Review

Validate your login